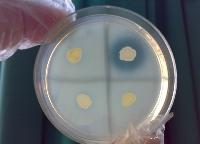

(一)治疗
自1970年代以来产生β内酰胺酶的MC菌株在美国和欧洲迅速增加,是细菌耐药性出现的一个实例。对产生β内酰胺酶的MC株,即使药敏实验对氨苄西林敏感也要避免应用氨苄西林,因为氨苄西林可诱导MC产生β内酰胺酶。MC所致许多感染均可口服抗生素治疗。MC对以下药物通常是敏感的:阿莫西林-克拉维酸、磺胺甲噁唑/甲氧苄啶(复方磺胺甲噁唑)、四环素、第二代口服头孢菌素、大环内酯类、氟喹诺酮类等。MC也对替卡西林、哌拉西林、注射用头孢菌素、氨基糖苷类抗生素敏感。对青霉素、氨苄西林、万古霉素、克林霉素和林可霉素耐药。因此对MC菌感染者,建议首选头孢唑林和(或)氨基糖苷类抗生素。此外,对于原发病的治疗,增强抵抗力、加强营养支持疗法等亦十分重要。
(二)预后
患者多有基础疾病如肺心病、肿瘤、糖尿病等。病死率高达21%。